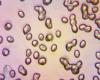
michenaspnya240911_t1.jpg

|
|
|
|
|
165

0524092011
Дата: 25.09.11
Добавлено: Tonya
Комментариев: 0
Просмотров: 1178
|
166

0524092011
Дата: 25.09.11
Добавлено: Tonya
Комментариев: 0
Просмотров: 1134
|
167

0624092011
Дата: 25.09.11
Добавлено: Tonya
Комментариев: 0
Просмотров: 1139
|
168

0624092011
Дата: 25.09.11
Добавлено: Tonya
Комментариев: 0
Просмотров: 1080
|
|
|
171

0724092011
Дата: 25.09.11
Добавлено: Tonya
Комментариев: 0
Просмотров: 1194
|
172

0724092011
Дата: 25.09.11
Добавлено: Tonya
Комментариев: 0
Просмотров: 1171
|
173

0824092011
Дата: 25.09.11
Добавлено: Tonya
Комментариев: 0
Просмотров: 1204
|
174

0824092011
Дата: 25.09.11
Добавлено: Tonya
Комментариев: 0
Просмотров: 1133
|
175

02191011
Дата: 04.01.12
Добавлено: Tonya
Комментариев: 0
Просмотров: 1199
|
176

02191011
Дата: 04.01.12
Добавлено: Tonya
Комментариев: 0
Просмотров: 1152
|
177

03191011
Дата: 04.01.12
Добавлено: Tonya
Комментариев: 0
Просмотров: 994
|
178

04191011
Дата: 04.01.12
Добавлено: Tonya
Комментариев: 0
Просмотров: 1050
|
179

05191011
Дата: 04.01.12
Добавлено: Tonya
Комментариев: 0
Просмотров: 1061
|
180

06191011
Дата: 04.01.12
Добавлено: Tonya
Комментариев: 0
Просмотров: 1038
|
181

07191011
Дата: 04.01.12
Добавлено: Tonya
Комментариев: 0
Просмотров: 1098
|
182

08191011
Дата: 04.01.12
Добавлено: Tonya
Комментариев: 0
Просмотров: 1114
|
183

09191011
Дата: 04.01.12
Добавлено: Tonya
Комментариев: 0
Просмотров: 1084
|
184

10191011
Дата: 04.01.12
Добавлено: Tonya
Комментариев: 0
Просмотров: 1110
|
185

11191011
Дата: 04.01.12
Добавлено: Tonya
Комментариев: 0
Просмотров: 1059
|
186

12191011
Дата: 04.01.12
Добавлено: Tonya
Комментариев: 0
Просмотров: 1127
|
187

01191011
Дата: 04.01.12
Добавлено: Tonya
Комментариев: 0
Просмотров: 1167
|
188

01191011
Дата: 04.01.12
Добавлено: Tonya
Комментариев: 0
Просмотров: 1173
|
|
|
|
|
|
|
|
|
|
|
|
|
|
200

01010412
Дата: 05.06.12
Добавлено: arfey
Комментариев: 0
Просмотров: 1633
|
















































 грибы
грибы фотогалерея
фотогалерея флора
флора фауна
фауна птицы
птицы млекопитающие
млекопитающие пресмыкающиеся
пресмыкающиеся земноводные
земноводные бабочки
бабочки насекомые
насекомые рыбы
рыбы видео
видео казахстан
казахстан кулинария
кулинария статьи
статьи ссылки
ссылки о нас
о нас